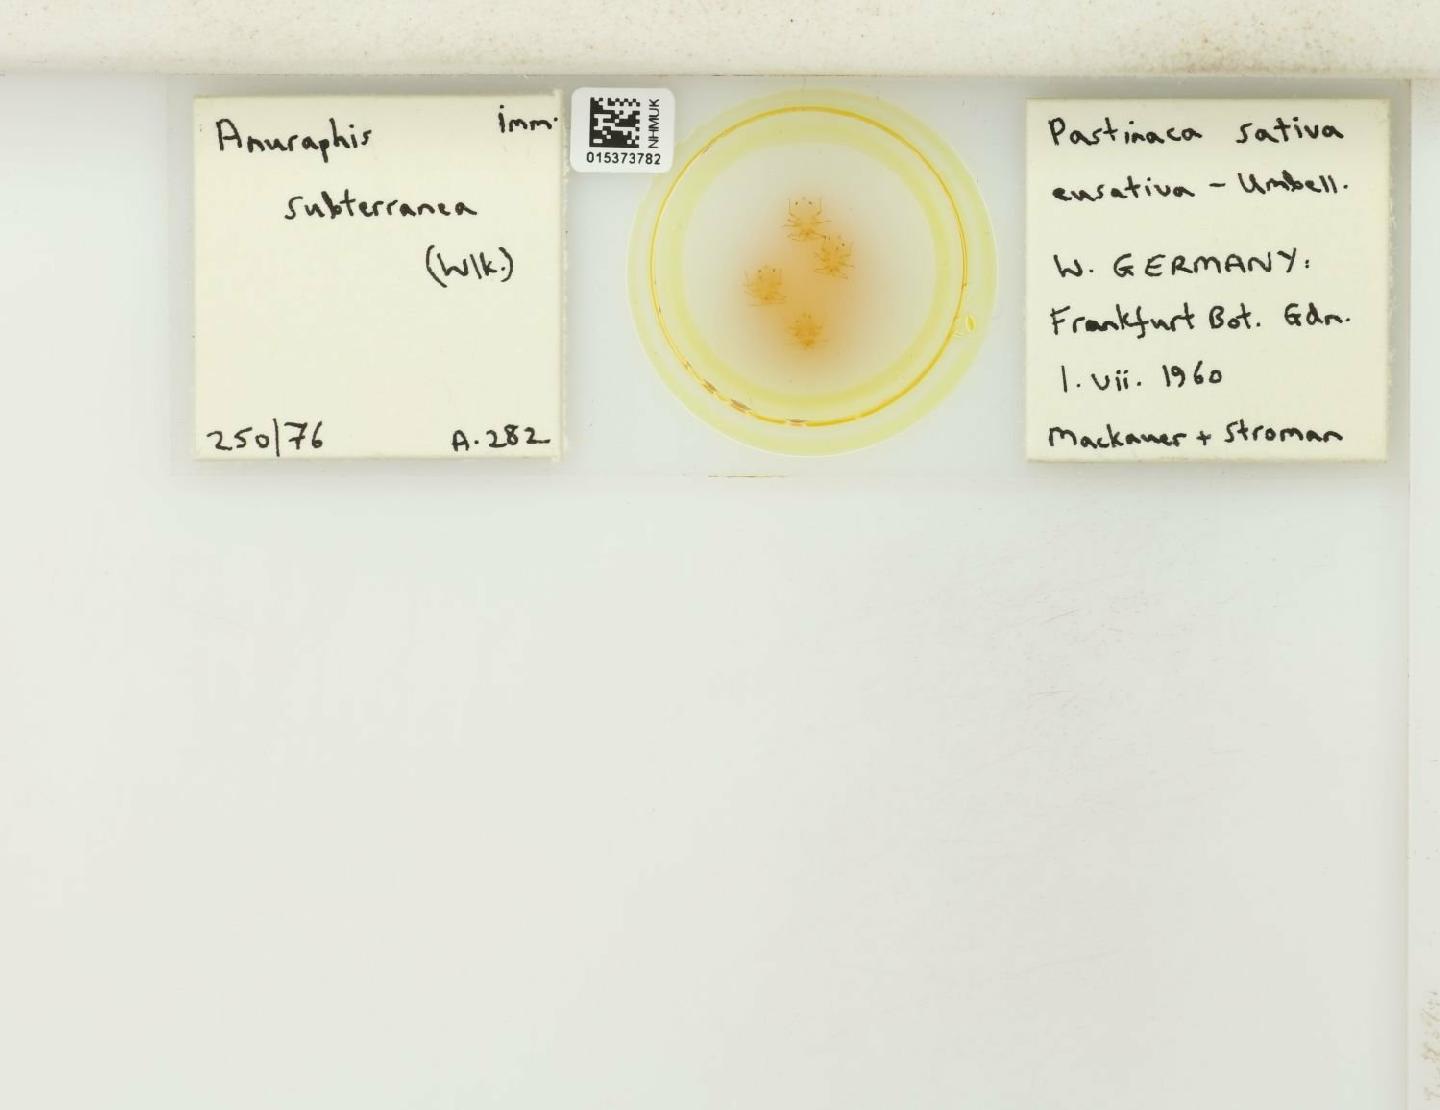

Espèces 13585 à 13600 sur 28734
Anuraphis farfarae
Koch, 1854
107 occurrences
107 medias

Anuraphis subterranea
Walker, 1852
396 occurrences
396 medias
Anuromyzus cotoneasteris
Shaposhnikov, 1959
32 occurrences
32 medias

Aphidura corsicensis
Nieto Nafría, Blackman & Martin, 2014
7 occurrences
7 medias

Aphidura delmasi
Remaudière & Leclant, 1965
28 occurrences
28 medias

Aphidura gallica
Nieto Nafría, Mier Durante & Remaudière, 2013
3 occurrences
3 medias

Aphidura ornata
Hille Ris Lambers, 1956
13 occurrences
13 medias

Aphidura pujoli
Gómez-Menor, 1950
22 occurrences
22 medias

Aspidaphis adjuvans
Walker, 1848
79 occurrences
79 medias

Aspidaphis porosiphon
Börner, 1950
66 occurrences
66 medias

Aulacorthum circumflexum
Buckton, 1876
538 occurrences
538 medias

Aulacorthum flavum
F.P. Müller, 1958
16 occurrences
16 medias

Aulacorthum rufum
Hille Ris Lambers, 1947
59 occurrences
59 medias

Aulacorthum solani
Kaltenbach, 1843
1199 occurrences
1199 medias

Aulacorthum speyeri
Börner, 1939
42 occurrences
42 medias

Brachycaudus aconiti
Mordvilko, 1928
20 occurrences
20 medias
